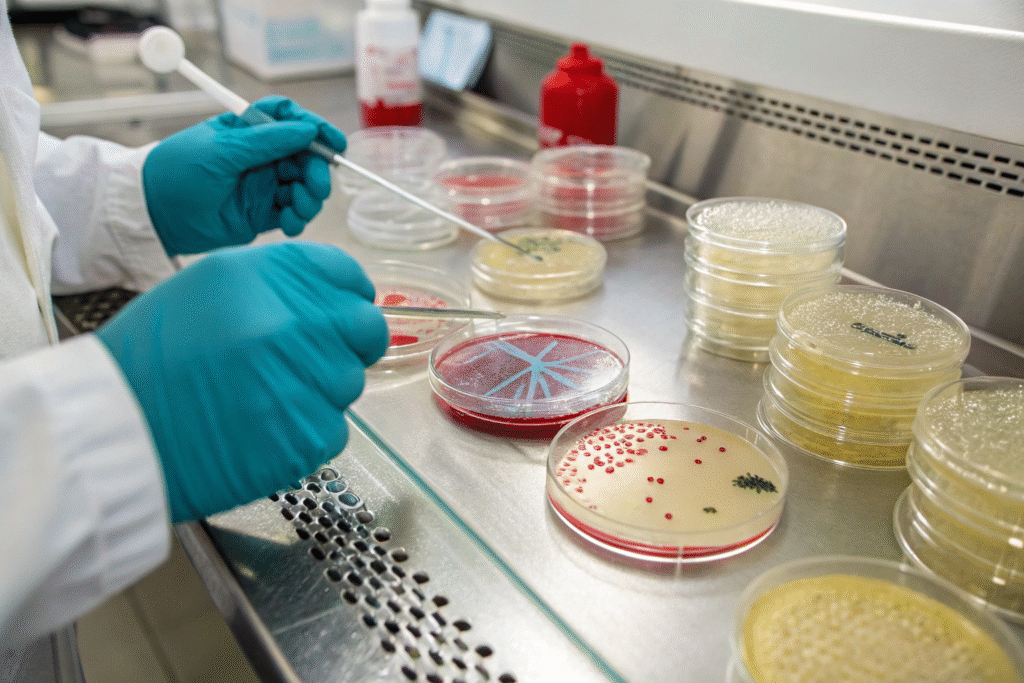

Sutures are essential tools in modern medicine, ensuring wounds heal properly and surgical outcomes remain safe. Traditionally, non-dissolving stitches had to be manually removed, often causing discomfort and requiring additional clinical visits. The introduction of quick-dissolving stitch threads has transformed this process, offering greater comfort and faster recovery for patients. Recent innovations in materials and textile engineering are taking these sutures even further, making them smarter, safer, and more sustainable.
The latest developments in quick-dissolving stitch threads include biodegradable polymers, antibacterial coatings, smart drug-delivery functions, and eco-friendly production methods. Together, these advances improve patient safety, reduce infection risks, and align with sustainable medical practices.
In the sections below, I will outline the main breakthroughs in dissolvable sutures, explain their medical benefits, and highlight how manufacturers are shaping the next generation of surgical threads.
Biodegradable Polymers For Safer Healing
One of the most significant innovations in dissolvable sutures is the use of biodegradable polymers such as polyglycolic acid (PGA), polylactic acid (PLA), and their copolymers. These materials provide controlled tensile strength during the healing phase and then naturally break down within the body.
By gradually dissolving into harmless by-products, these polymers eliminate the need for suture removal and reduce patient discomfort.
They are especially valuable in internal procedures where removing stitches would be complex or risky.

How Do Biodegradable Sutures Function?
These sutures degrade through hydrolysis when exposed to bodily fluids, eventually converting into carbon dioxide and water. According to NCBI, PGA-based sutures maintain strength for 2–4 weeks before dissolving fully in 60–90 days, depending on the formulation.
Why Are They Better Than Traditional Sutures?
They reduce the need for follow-up removal visits, minimize scarring, and lower the risk of foreign body reactions. This makes them safer and more convenient, especially for patients recovering from complex surgeries.
Antibacterial And Infection-Resistant Coatings
Infection control remains a top priority in surgery, and sutures can be a point of vulnerability. To address this, researchers have developed dissolvable sutures with antibacterial coatings such as triclosan or silver nanoparticles.
These coatings actively inhibit bacterial growth around the wound, lowering the risk of infection and improving recovery outcomes.
By combining biodegradability with infection resistance, these sutures provide dual protection for patients.
How Effective Are Antibacterial Sutures?
Research published in The Lancet shows that triclosan-coated sutures can reduce infection rates by up to 30%. They are particularly effective in abdominal and orthopedic procedures, where infection risks are higher.
Are Antibacterial Sutures Safe For Patients?
Yes. Regulatory approvals from FDA and certifications like OEKO-TEX confirm that antibacterial sutures are safe, biocompatible, and free from harmful residues when properly manufactured.
Smart Sutures With Drug-Delivery Functions
Another breakthrough in dissolvable threads is the creation of "smart sutures" that combine wound closure with localized therapy. These sutures are embedded with antibiotics, pain relievers, or growth factors that release gradually as the material dissolves.
This dual purpose helps close wounds while also enhancing recovery by delivering targeted medication directly to the site.
They are particularly valuable in surgeries where systemic medication is less effective or where infection control is critical.

How Do Drug-Delivery Sutures Work?
Therapeutic compounds are encapsulated within polymer microcapsules or nanofibers. As the suture dissolves, these compounds are gradually released into surrounding tissue. Research from Nature reports sutures that can provide sustained antibiotic release for up to 10 days.
What Procedures Benefit Most From Them?
They are useful in gastrointestinal, dental, and orthopedic surgeries—procedures where infection prevention and rapid healing are especially important.
Eco-Friendly And Next-Generation Manufacturing
Beyond clinical performance, sustainability has become a focus in suture innovation. Manufacturers are now developing sutures from renewable polymers and adopting greener production methods.
These practices reduce environmental impact while ensuring medical-grade safety and durability.
Next-generation production techniques are also enabling the creation of finer, smoother threads that cause less tissue trauma and improve surgical precision.

How Are Sutures Becoming More Sustainable?
Producers are using plant-based polymers and closed-loop water systems to reduce waste. According to ScienceDirect, innovations in green chemistry are making it possible to manufacture sutures with lower carbon footprints.
What Benefits Do Next-Generation Methods Provide?
They allow sutures to be thinner yet stronger, ideal for delicate surgeries such as ophthalmology and cardiovascular procedures where accuracy and minimal tissue damage are critical.
Conclusion
Quick-dissolving stitch threads have advanced far beyond simple biodegradable designs. Modern innovations now combine biodegradable polymers, antibacterial coatings, smart drug-delivery systems, and eco-friendly production methods. These improvements not only enhance patient safety and comfort but also reduce healthcare costs and align with sustainability goals.
As medical technology continues to evolve, these sutures will play an increasingly important role in improving surgical outcomes. Manufacturers and healthcare providers adopting these innovations will be better equipped to meet both clinical and environmental needs in the future.














